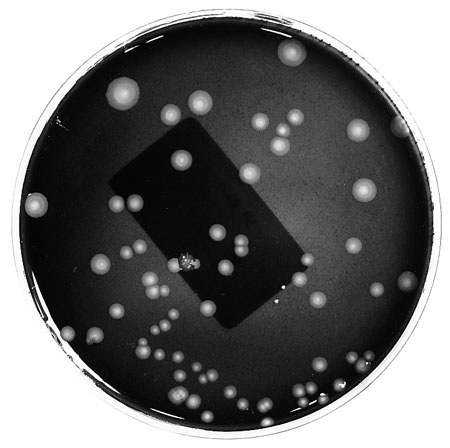

Bakterien im Trinkwasser
.
Trinkwasser genießt als Lebensmittel Nummer Eins einen ausgezeichneten Ruf. Es wird streng kontrolliert und ist auch bei Genuss in jedem Fall unbedenklich. Hieraus leitet sich die Annahme ab, Wasser sei steril. Tatsächlich aber, ist im Nass richtig was los. Lesen Sie hier, was in einem Wassertropfen so abgeht.
.

.
Nach den Festlegungen der Trinkwasserverordnung dürfen durchaus Bakterien im Trinkwasser vorhanden sein. Und das gilt sogar für solche, die als Krankheitserreger zu bewerten sind. Sie dürfen allerdings nicht in einer Konzentration vorkommen, die eine Gefahr für die Gesundheit darstellt. So werden folglich Bakterien als natürlicher Bestandteil des Wassers „frei Haus“ geliefert. In der Haustechnik dürfen sich diese freilich nicht so stark vermehren, dass von ihnen eine Gefahr ausgehen kann.
.
Mikrobiologie - ein neumodischer Kram?
Ein nahezu klassisches Beispiel für kleine Wasserbewohner sind die Lebewesen, die man gemeinhin als Legionellen bezeichnet. Sie sind in jedem Süßwasser zu finden - von der Pfütze über Fluss und See, bis hin zum Trinkwasser. Im Kaltwasser ist ihre Anzahl so gering, dass sie dem Menschen nicht gefährlich werden können. Finden sie jedoch ideale Lebensbedingungen, vermehren sie sich durch Teilung. Und dann können diese für den Nutzer einer Trinkwasserinstallation gefährlich werden. Oft wird dazu festgestellt, dass das Thema Trinkwasser und Bakterien in die Kategorie „neumodischer Kram“ gehört. Der alte Meister merkt an, dass es so einen Blödsinn zu seiner Zeit nicht gegeben hat. Und... er hat Recht. Früher beschränkte sich der sanitäre Luxus auf je eine Entnahmestelle für Kaltwasser im Treppenhaus pro Etage. Schlechte Zeiten für Legionellen. Kaltes Wasser, keine wenig durchflossenen Leitungsbereiche, also auch keine Chance zur Gründung einer bakteriellen Großfamilie. Später wendete sich dieses Blatt. Die Wassererwärmung im Gebäude wurde zum Standart. Und in den 70iger Jahren des vergangenen Jahrhunderts dümpelten im Schatten der Energiekrise abertausende zentrale Wassererwärmungsanlagen mit 45 °C vor sich hin. Eine Sternstunde der kleinen Plagegeister. Optimale Lebensbedingungen animierten zur exzessiven Teilung und schwunghaften Bestandsvermehrung. Die Legionellen wurden so zum Risiko für die Hausbewohner.
.

.
Feine Technik - fiese Bakterien
Aber nicht nur die mäßigen Warmwassertemperaturen trugen zur Vermehrung bei. Quasi zeitgleich wurde auch die Technik graziler. Wo früher eine Handbrause mit zehn Löchern genügte, konnte fortan nur eine solche mit mindestens vier verschiedenartig einstellbaren Brausestrahlarten punkten. Das dafür erforderliche Brausen-Innenleben schaffte zusätzlich eine Kinderstube für die winzigen Störenfriede. Denn in den Benutzungspausen konnten sich hier die stäbchenförmigen Bakterien im Temperaturbereich von 30 bis 45 °C stark vermehren. Genauso wie im lauwarm vor sich hin dümpelnden Wassererwärmer. Dem Problem tritt man heute mit Anlagen entgegen, die an keiner Stelle Wassertemperaturen unter 60°C aufweisen dürfen. Auf diese Weise will man den Legionellen den Spaß an der Zellteilung und folglich Mehrung nehmen. Schließlich ist eine hohe Konzentration von Legionellen im Wasser alles andere als ungefährlich. Vom Menschen aufgenommen über fein vernebelte Wassertröpfchen (Aerosol) können sie Auslöser des Pontiac-Fiebers sein. Diese Erkrankung ist einer Grippe ähnlich. Der Betroffene quält sich mit Fieber und mit Kopfschmerzen herum, aber nach ein paar Tagen klingen die Beschwerden - auch ohne Behandlung wieder ab. Ungleich gefährlicher ist es, wenn man sich die zweite, durch Legionellen hervorgerufene Krankheit einhandelt - die Legionellenpneumonie, auch als Legionellose bezeichnet. Sie bringt die Symptome einer sehr schweren Lungenendzündung mit sich und führt unbehandelt nicht selten zum Tode. Heute weiß man zudem, dass Legionellen auch über Wunden aufgenommen werden können und dann im Körper ihr Unwesen treiben. Besonders für den immungeschwächten Menschen (z. B. nach einer Operation) kann diese Art der Infektion zum Problem werden.
.

.
Es sind nicht nur die Legionellen
Während sich die Legionellen, diese kleinen Viecher, im Rahmen der geschilderten Erkenntnisse lange im Licht der Öffentlichkeit suhlten, wurden andere Wasserbewohner einfach übersehen. Die Rede soll hier sein von den Pseudomonas aeruginosa, einem Nasskeim, der nicht nur aber auch im Trinkwasser sein zuhause findet. Im Gegensatz zu den Legionellen fühlt er sich auch in kaltem Wasser wohl. Wie man heute weiß, findet bei diesem stäbchenförmigen Bakterium eine Teilung (also Vermehrung) auch im Temperaturbereich unterhalb von 20 °C statt. Da sich der Kamerad damit im gesamten Leitungssystem wohlfühlt, breitet er sich - einmal eingebracht - in der gesamten Trinkwasser-Hausinstallation sehr schnell aus. Die „Infektion“ der Installation kann dabei schon mittels eines kontaminierten Putzlappens erfolgen, mit dem z. B. eine Entnahmearmatur gereinigt wird. Denn schließlich kann Pseudomonas aeruginosa überall dort vorkommen, wo es feuchte Oberflächen gibt (beispielsweise auf Dusch- und Badewannen, Toiletten, Fliesenböden). Ein Eintrag dieser Bakterie ins System ist auch durch den Einbau kontaminierter Bauteile denkbar. Etwa das Rohr, das auf der Baustelle aus Versehen erst einmal in einer Pfütze gelandet war, bevor es zur Trinkwasserleitung „befördert“ wurde. Das Bakterium aus der Installation wieder auszutreiben dürfte erfahrungsgemäß nicht so leicht sein. Während eine Legionelle normalerweise bei Wassertemperaturen von mehr als 60 °C das Ableben bevorzugt, zeigen sich Pseudos davon unbeeindruckt; sie muss man schon buchstäblich kochen, um ihnen den Löffel abzunehmen.
.

.
Escherichia coli und Konsorten
Eine Infektion mit Pseudomonas aeruginosa kann Lungenentzündungen, Wundinfektionen und Blutvergiftungen hervorrufen. Bei gesunden Menschen kann die Bakterie meist wenig ausrichten. Gefährdet sind hier wiederum die Patienten in Krankenhäusern, die diesem Bakterium nicht genügend Abwehr entgegensetzen können. Im Risikofokus stehen hier vor allem Mukoviszidose-Patienten, Patienten mit Bronchialerkrankungen und solche mit Meningitis oder Nierenleiden sowie Transplantationsempfänger. Darmentzündungen und Durchfall bei immungeschwächten Personen können Escherichia coli (kurz E.coli) verursachen. Kommen sie im Trinkwasser eines Systems vor, muss man sie als Indikator für fäkale Verunreinigungen des Wassers deuten. Denn E.coli sind Bakterien, die im Darm von Mensch und Tier existieren und dort tatsächlich die Verdauung unterstützen. Ferner produzieren sie Vitamin K, was eine wichtige Rolle zum Erhalt des Immunsystems spielt. Taucht das Bakterium allerdings im Trinkwasser auf, ist Vorsicht geboten. Es zeigt, dass eine Wasserverunreinigung stattfindet, deren Ursache bis dato unbekannt ist. Auch das Vorhandensein von Enterokokken lässt diesen Schluss zu. Enterokokken gehören zu den Milchsäure-Bakterien und kommen ebenfalls im Verdauungstrakt vor. In einwandfreiem Trinkwasser dürfen sich weder E.coli noch Enterokokken befinden. Die Koloniezahl dieser Bakterien muss also Null sein.
.
.
Die Bakterien-Kolonien zählen
Die Koloniezahl sagt aus, wie viele koloniebildende Einheiten (KBE) pro Volumeneinheit (meist Milliliter) im Trinkwasser vorhanden sind. Gießt man eine Wasserprobe auf einen Nährboden und schafft für das Bakterium optimale Lebensbedingungen (Legionellen kommen zum Beispiel in einen muckeligen Wärmeschrank), ist jedes einzelne Bakterium in der Lage, sich zu teilen. Es beginnt damit eine Kolonie zu bilden. Dann entstehen auf dem Nährboden rundliche, mit dem bloßen Auge erkennbare Gebilde, die ein wenig an Schimmel erinnern. Diese zählt man und kann so Rückschlüsse darauf ziehen, wie viele KBE in der untersuchten Wasserprobe vorhanden sind. Dabei ist ein Wert auch heute noch anerkannt und gebräuchlich: Nämlich die magische Zahl von 100 KBE. Dieser Wert wurde um etwa 1880 von Robert Koch festgelegt. Er besagt, dass Bakterienansammlungen bis zu 100 KBE keine Epidemien auslösen können. Im Gegensatz zu den chemischen Begleitstoffen, die sich im Wasser einer Hausinstallation (abgesehen von Blei, Nickel und Kupfer) nicht verändern, sieht es in Sachen der Mikrobiologie ganz anders aus. Hier entscheiden die Betriebsbedingungen und die Konstruktion der Trinkwasserleitungen darüber, ob ein eingebrachtes einzelnes (also harmloses) Bakterium gefrustet eingeht, ein weiterhin unbedeutendes Leben führt oder sich gefährlich vermehrt. Oft können nur Kleinigkeiten in Sachen der Konstruktion und der Betriebsbedingungen entscheidend sein, wie etwa die Stagnationszeiten in einem Leitungsteil oder die Temperatur, auf die sich das stehende Wasser erwärmt.
.
Um das bunte mikroskopische Treiben im Trinkwasser jederzeit unter Kontrolle zu halten, sollte sich der Anlagenmechaniker im Bereich der Biologie daher auch ein wenig auskennen. Denn wenn man von den Vorlieben und Aversionen der kleinen Wasserbewohner weiß, kann man die Installationsregeln und Vorschriften bezüglich der Betriebsbedingungen, die uns Normen und DVGW-Arbeitsblätter vorgeben, viel besser verstehen - und vor allem auch zielgerichtet umsetzen.
.
.
von Jörg Scheele†2011
RIP mein Freund






